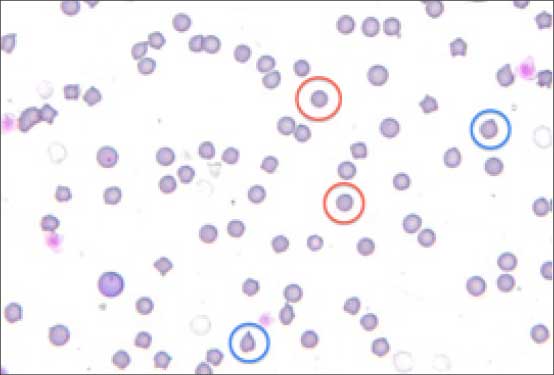
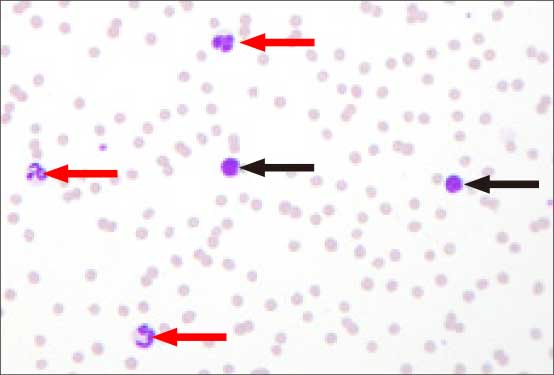
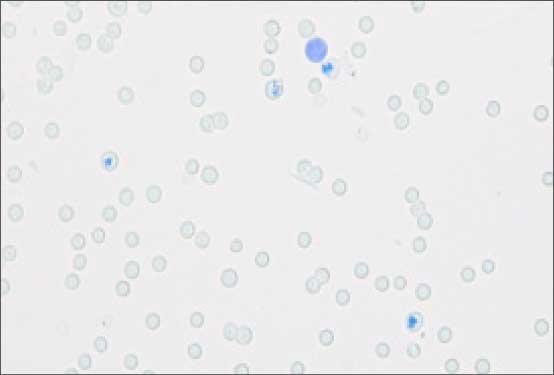
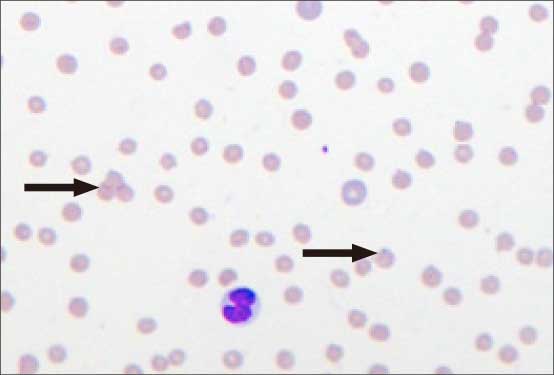
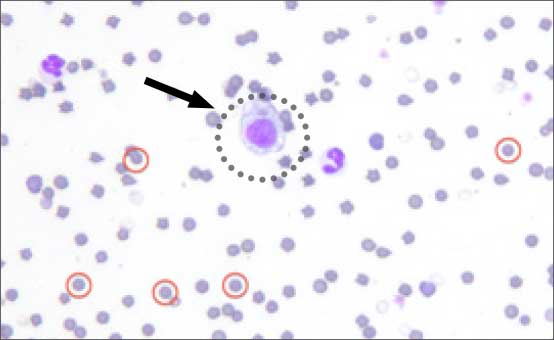

診察の流れ
問診・身体検査
まずは一般的な問診や身体検査から全身状態を確認します。
体温(白血球の増減を伴う発熱や低体温)、可視粘膜の色調(貧血では蒼白、血小板の異常時には点状出血)、紫斑(血小板の異常)、関節の腫脹や内出血(凝固異常)、ノミの予防歴などは以降の検査と併せて重要な情報となります。また、貧血がある場合には、聴診で心雑音が聴取されることがあります。

貧血により蒼白化した粘膜

紫斑
検査
全血球数算定(CBC)
全血球成分、つまり、赤血球、白血球および血小板の数や性状を数値化する検査です。赤血球においてはその大きさや濃さも数値化され、その数値から、貧血や多血の有無を判定します。さらに、貧血が存在する場合には、新しい赤血球を生産している『再生性貧血』と、生産していない『非再生性貧血』の分類を行う際の一助となります。
白血球においてはその増減と内訳から多くの情報が得られます。一般的に白血球数の増加は感染や炎症などを示唆し、減少は敗血症や骨髄の問題などを示唆し、易感染性の危険性があります。
また、白血球はさらにその形態から好中球、好酸球、好塩基球、リンパ球、単球という細胞に細分類され、その内訳は病態の把握に重要な役割を果たします。
血小板においてはその減数が問題となる事が多く、動物に紫斑や点状出血が見られる際にはその数値は非常に重要です。いずれの血球成分に異常が見られる場合でも原因の追求が必要であり、それには以下のような検査を的確に組み合わせて総合的な判断を行うことが必要です。
血液塗抹検査
血液を顕微鏡で確認する検査です。赤血球の形態学的変化からは様々な疾患を診断できます。
例えば
- ハインツ小体(写真1:青丸):タマネギ中毒 など
- 球状赤血球(写真1:赤丸):免疫介在性溶血性貧血 など
- 標的赤血球(写真2):肝障害 など
- 破砕赤血球:血管肉腫、フィラリア症、DICなど

写真1

写真2
また、赤血球内に寄生体の存在を確認出来る事もあります。この他、赤血球の大小不同や染色性の多様性から再生性の有無を確認することもできます。
白血球の評価も非常に重要です。先に述べた白血球の分類を確認することで、炎症の急性/慢性の判定にも有用なほか、様々な疾患を診断できます。
例えば増加している細胞の種類により、
- 好中球(写真3:赤矢印):感染炎症
- 好酸球:アレルギー、寄生虫感染
- 好塩基球:アレルギー、肥満細胞腫
- 単球:慢性炎症
- リンパ球(写真3:黒矢印):慢性炎症、免疫介在性疾患、など

写真3
この他、細胞質内に特徴的な寄生体が確認出来ることもあります。
血小板の塗抹上での評価も重要です。血小板のサイズや数の確認をすることでその機能の評価につながることがあります。以上のように血球成分の異常を直接眼で見て判断することで、病態の把握につながります。
ニューメチレンブルー染色
特殊な染色を行うことで、再生している赤血球を明確に目視することができます。再生途中の赤血球は網状赤血球といわれ(写真4)、この数から算定する網状赤血球指数(RPI)というものから『再生性貧血』と『非再生性貧血』の鑑別を行います。この他、ハインツ小体(写真5:矢印)やハウエルジョリー小体、あるいは赤血球への寄生体を染色し、より明瞭に確認することができます。

写真4
(青色に染色されている血球が網状赤血球)

写真5
赤血球自己凝集試験
血液を生理食塩水を用いて希釈した際、赤血球の凝集が見られる場合を自己凝集と判定し、免疫介在性溶血性貧血(IMHA) が示唆されます。
クームス試験
主に免疫介在性溶血性貧血(IMHA) の診断の際に行います。
特殊な検査のため、外部の検査機関に血液を送付し、検査を依頼します。
PT.APTT(プロトロンビン時間、活性化部分トロンボプラスチン時間)
血液の凝固能を測定する検査です。
血液の凝固には様々な因子が複雑に関わる凝固カスケードというものが存在し、そのきっかけは内因性と外因性に大別されます。内因性の凝固カスケードの判定はAPTT、外因性はPTの測定によりなされます。この検査に異常が見られる場合には凝固能の異常が示唆され、異常の組み合せにより、止血における凝固因子の欠乏などを検出するのに役立ちます。
骨髄検査(骨髄穿刺、骨髄生検)
骨髄は血球成分の産生の場であるため、この検査により各血球成分の生産や成長が正常に進んでいるのかを判断します。血液検査や血液塗抹検査などで異常が見られるものの、その原因が特定出来ない場合に行います。また、血球異常が見られない場合でも骨髄に病変の存在が疑われる疾患の診断の際に行います。
尿検査
尿検査による腎機能の評価から腎性の非再生性貧血を疑うことや、出血が認められれば泌尿器系の臓器からの失血による貧血を疑うことも可能です。
この他、尿糖や尿中ビリルビンの検出が病態の把握の一助となることがあります。
X線検査/超音波検査
胸部および腹部のX 線検査および超音波検査を行うことで、体腔内の出血の確認や、血液上の異常を呈するような腫瘤の確認が可能です。また、肝臓や脾臓の腫大は免疫介在性疾患などに伴う血管外溶血といった赤血球の破壊や、髄外造血といって骨髄以外での血球成分の生産を示唆することがあります。
以上のような検査を踏まえて、どの血球成分にどのような異常があるのか、また、その異常の原因は何処にあるのかを把握し、病態に合わせた的確な治療を行っていくことが必要です。
例えば『貧血』と一口に言ってもその原因は様々ですが、まずは貧血の分類を行い、この分類から考えられる原因を絞り込みます。そしてさらに、その原因を特定するための詳しい検査を行っていきます。





 貧血により蒼白化した粘膜
貧血により蒼白化した粘膜
 紫斑
紫斑
写真1
写真1
 写真2
写真2
写真3
写真3
写真4(青色に染色されている血球が網状赤血球)
写真4(青色に染色されている血球が網状赤血球)
写真5
写真5

赤丸:球状赤血球 黒矢印:赤血球貪食像
赤丸:球状赤血球 黒矢印:赤血球貪食像